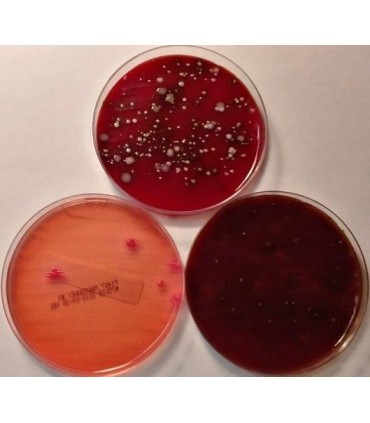
Análisis Bacteriológico Estanque (Bta)

Medición de la calidad higiénica de la leche.
Lee masMostrar menos
Código producto:
81000356
Favorito0

dfghjkl
Análisis que permite evaluar varios aspectos que influyen en la calidad de la leche, como higiene y manejo del estanque, temperatura del lavado del equipo de ordeña, rutina de ordeña y salud mamaria del rebaño.
Considera los siguientes parámetros: Recuento bacteriano total, recuento bacterias psicrótrofas, termodúricas, E. coli, coliformes totales, S. aureus, SCN, estreptocococos, entre otros, se utiliza muestra de estanque predial.
Comentarios
Sin comentarios